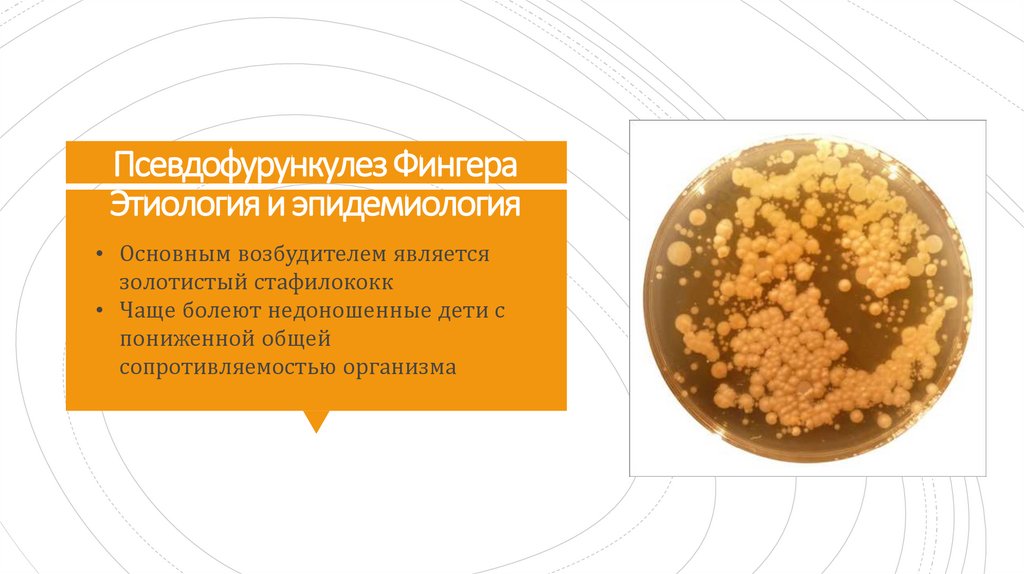

Similar presentations:
Абсцессы и флегмона новорожденных
1.
Абсцессы и флегмонановорожденных
Подготовила Цветкова А.П
2.
Абсцессы новорожднных(псевдофурункулез) – заболевание детей
инфекционной этиологии, при котором
поражаются выводные протоки и
клубочки эккринных потовых желез
Определения
Некротическая флегмона
новорожденных ( НФН) – это
острое гнойно-некротическое
воспаление подкожно-жировой
клетчатки.
3.
Псевдофурункулез ФингераЭтиология и эпидемиология
• Основным возбудителем является
золотистый стафилококк
• Чаще болеют недоношенные дети с
пониженной общей
сопротивляемостью организма
4.
Инфекция может захватывать толькоотверстие выводного протока потовой
железы. Затем образовываются
поверхностные пустулы (перипорит)
Клиника
псевдофурункулеза
5.
КЛИНИКА• Значительно чаще поражается весь
проток и клубочки потовой железы
• Образуются многочисленные узлы,
плотные, резко отграниченные,
красно-синеватого цвета.
• Генерализация процесса в редких
случаях может привести к сепсису
6.
7.
В первые часы развития на коже появляетсяограниченный участок гиперемии диаметром 1,5-2
см, быстро расползаются по типу «масляного
пятна»
Некротическая
флегмона
новорожденного
Этиология
К началу 2х суток в центре багрово-синюшной
гиперемии выявляется размягчение
Затем образуются мелкие свищевые ходы с
серозно-гнойным отделяемым
Стихание происходит на 10-15 день
8.
9.
10.
Токсико-септическаяформа
Формы
заболевания
Простая форма

medicine
medicine








